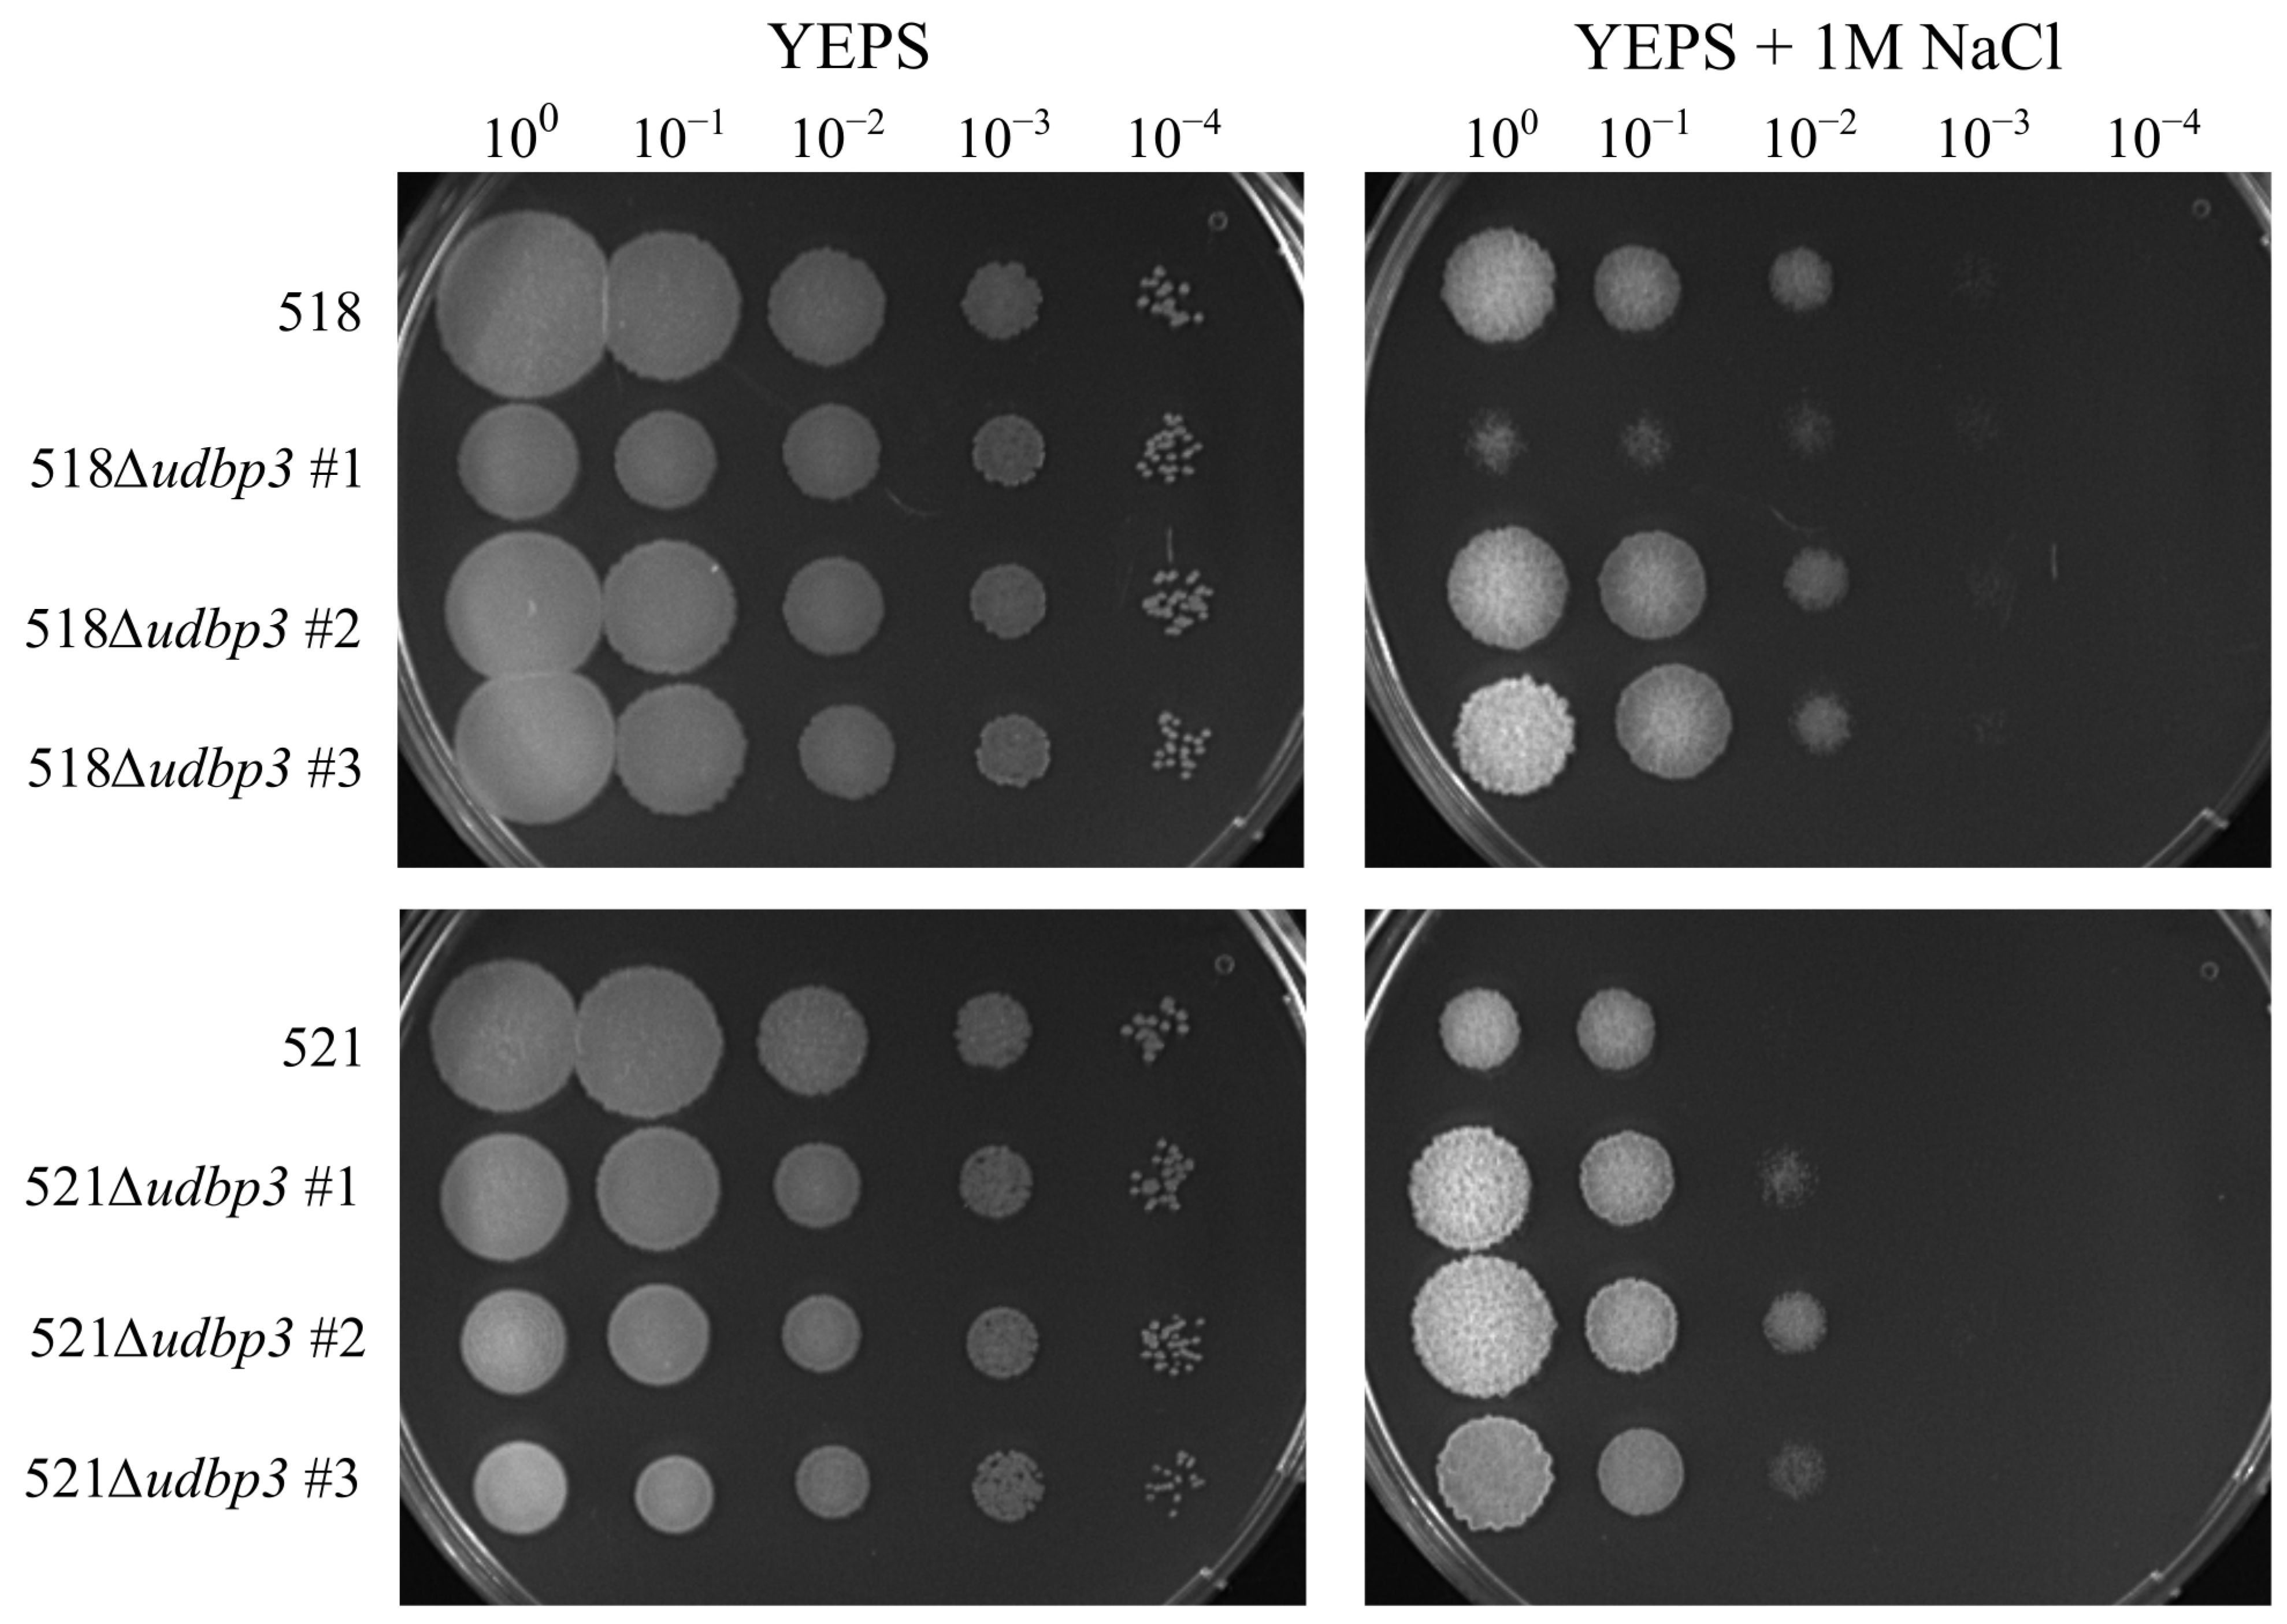
Ijms 26 02432 g003
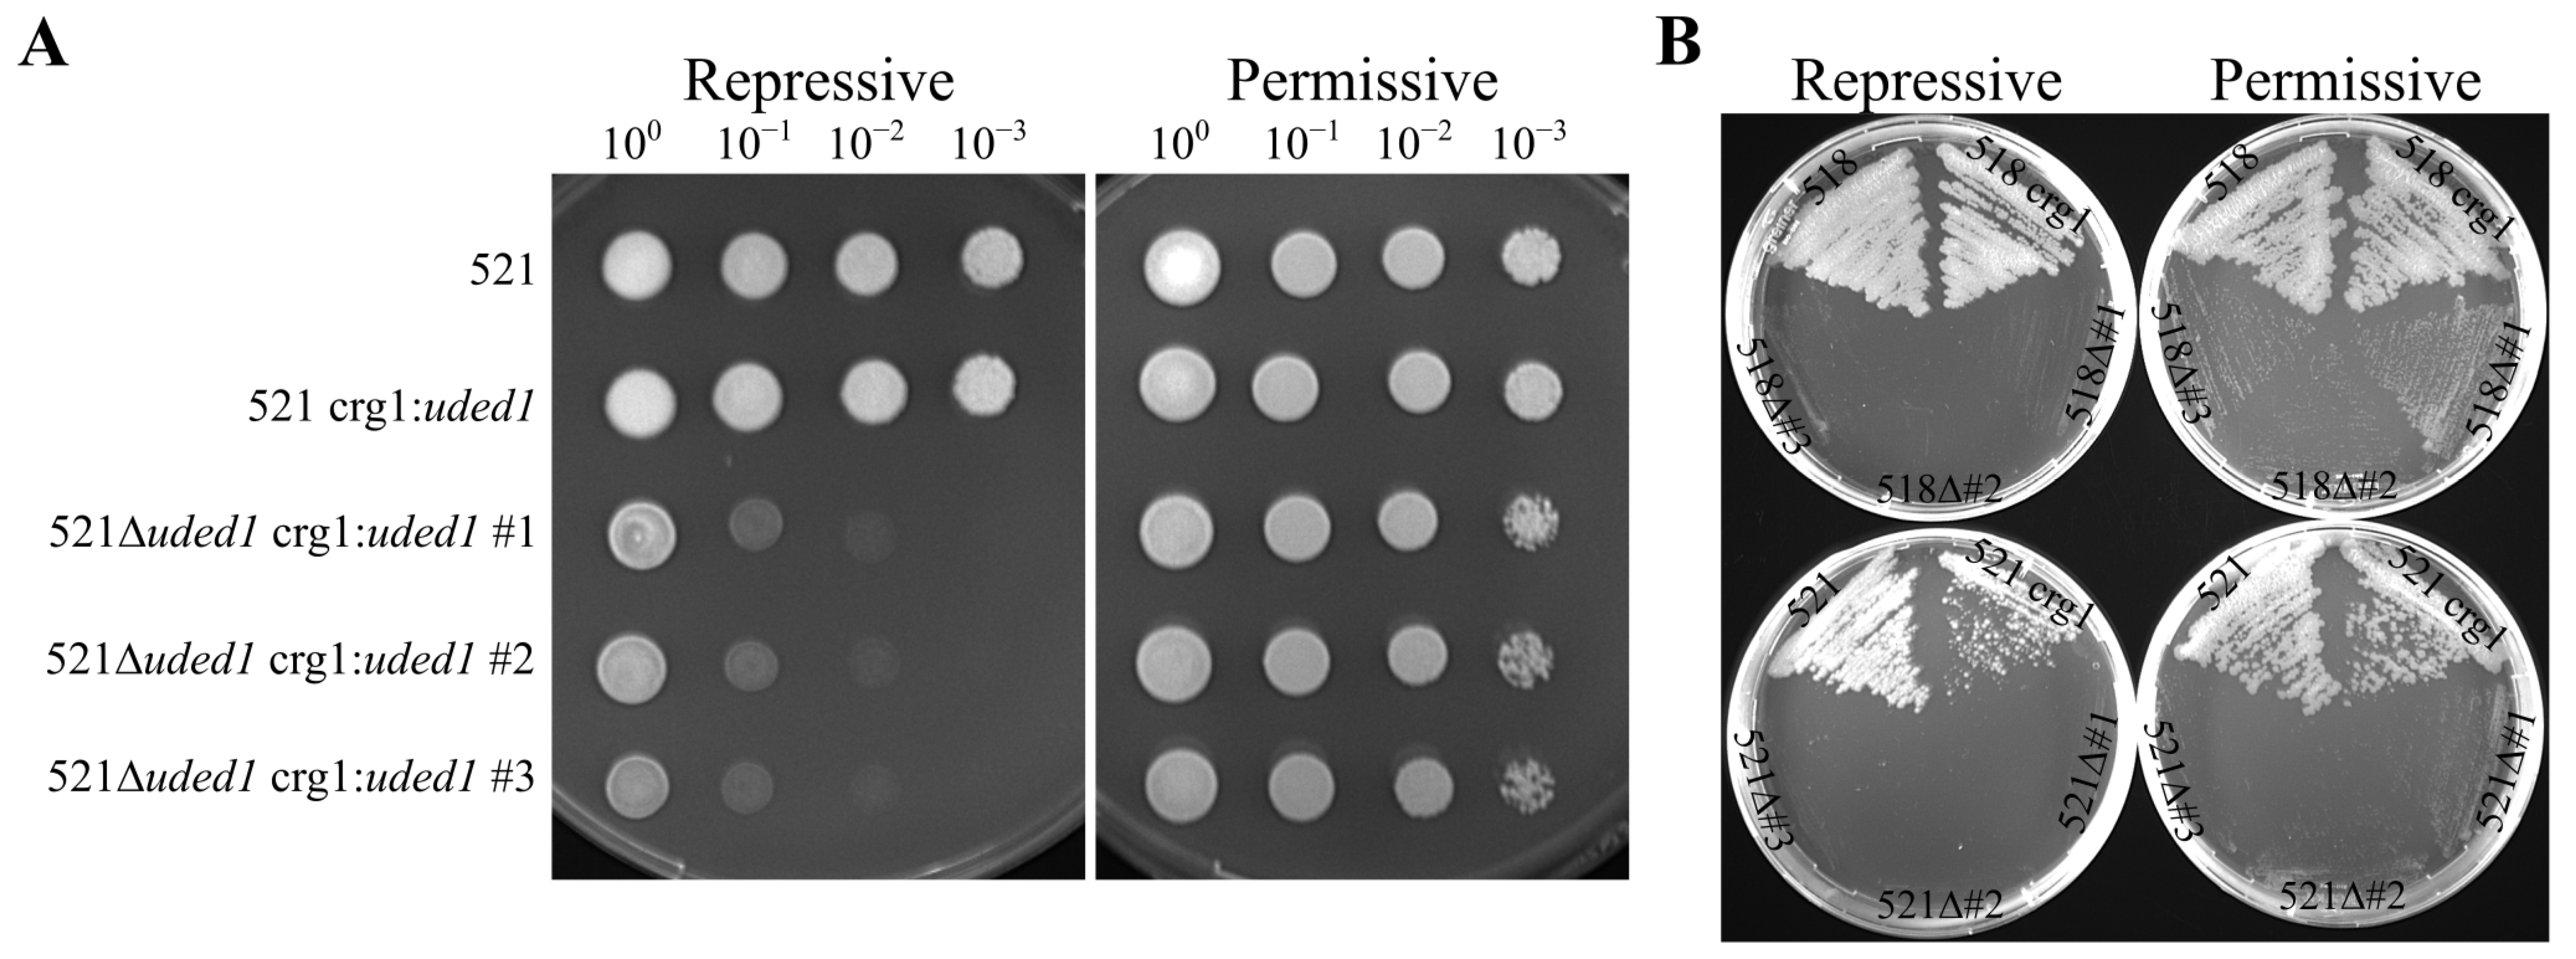
Ijms 26 02432 g004

Characterization of RNA Helicase Genes in Ustilago maydis Reveals Links to Stress Response and Teliospore Dormancy
Abstract
1. Introduction
2. Results
2.1. Identification of RNA Helicases with Potential Roles During Teliospore Germination
2.2. udbp3 Characterization
2.3. Deletion of uded1 Is Detrimental to Growth
2.4. The Ability for uded1 Mutants to Mate and Infect the Plant
2.5. Transcript Levels of uded1 in Mutants Grown in Repressive and Permissive Conditions
2.6. Impact of uded1 Expression on dsRNA Stability
3. Discussion
3.1. The Role of udbp3 in Osmotic Stress Response
3.2. The DED1 Ustilago maydis Ortholog Is uded1
3.3. Uded1’s Role in Translation Regulation
4. Materials and Methods
4.1. Ustilago maydis Strains and Growth Conditions
4.2. Bioinformatic Analysis
4.3. Creation of udbp3 Deletion Strains
4.4. Creation of an uded1 Ustilago maydis Ectopic Expression Strain
4.5. Creation of an uded1 Ustilago maydis Deletion Strain
4.6. Creation of as-ssm1-Expressing Strains
4.7. Total RNA Isolation, RT-PCR, and RT-qPCR
4.8. S1 Nuclease Protection Assay
4.9. Plate Mating Assays
4.10. Seedling Pathogenesis Assays
4.11. Stress Response Assays
4.12. Plate Growth Assays
Supplementary Materials
Author Contributions
Funding
Institutional Review Board Statement
Informed Consent Statement
Data Availability Statement
Acknowledgments
Conflicts of Interest
References
- Sussman, A.S.; Douthit, H.A. Dormancy in microbial spores. Annu. Rev. Plant Physiol. 1973, 24, 311–352. [Google Scholar] [CrossRef]
- Nautiyal, P.; Sivasubramaniam, K.; Dadlani, M. Seed dormancy and regulation of germination. Seed Sci. Technol. 2023, 52, 39–66. [Google Scholar]
- McDonald, M.D.; Owusu-Ansah, C.; Ellenbogen, J.B.; Malone, Z.D.; Ricketts, M.P.; Frolking, S.E.; Ernakovich, J.G.; Ibba, M.; Bagby, S.C.; Weissman, J.L. What is microbial dormancy? Trends Microbiol. 2024, 32, 142–150. [Google Scholar] [CrossRef] [PubMed]
- Banuett, F.; Herskowitz, I. Discrete developmental stages during teliospore formation in the corn smut fungus, Ustilago maydis. Development 1996, 122, 2965–2976. [Google Scholar] [CrossRef]
- Brefort, T.; Doehlemann, G.; Mendoza-Mendoza, A.; Reissmann, S.; Djamei, A.; Kahmann, R. Ustilago maydis as a pathogen. Annu. Rev. Phytopathol. 2009, 47, 423–445. [Google Scholar] [CrossRef]
- Ramberg, J.E.; McLaughlin, D.J. Ultrastructural study of promycelial development and basidiospore initiation in Ustilago maydis. Can. J. Bot. 1980, 58, 1548–1561. [Google Scholar] [CrossRef]
- Christensen, J.J. Corn Smut Caused by Ustilago maydis (Monograph No. 2); American Phytopathological Society: St. Paul, MN, USA, 1963; p. 41. [Google Scholar]
- Caltrider, P.G.; Gottlieb, D. Effect of sugars on germination and metabolism of teliospores of Ustilago maydis. Phytopathology 1966, 56, 479–484. [Google Scholar]
- Gottlieb, D. The physiology of spore germination in fungi. Bot. Rev. 1950, 16, 229–257. [Google Scholar] [CrossRef]
- Griffin, D.H. Spore dormancy and germination. In Fungal Physiology; John Wiley & Sons: New York, NY, USA, 1994; Volume 2, pp. 375–398. [Google Scholar]
- Gottlieb, D.; Rao, M.; Shaw, P. Changes in Ribonucleic Acid during the Germination of Teliospores of Ustilago maydis. Phytopathology 1968, 58, 1593–1597. [Google Scholar]
- Seshachalam, D. A protein-nucleic acid complex in teliospores of Ustilago maydis. Antonie van Leeuwenhoek 1974, 40, 265–274. [Google Scholar] [CrossRef]
- Donaldson, M.E.; Saville, B.J. Ustilago maydis natural antisense transcript expression alters mRNA stability and pathogenesis. Mol. Microbiol. 2013, 89, 29–51. [Google Scholar] [CrossRef] [PubMed]
- Ostrowski, L.A.; Saville, B.J. Natural antisense transcripts are linked to the modulation of mitochondrial function and teliospore dormancy in Ustilago maydis. Mol. Microbiol. 2017, 103, 745–763. [Google Scholar] [CrossRef] [PubMed]
- Bourgeois, C.F.; Mortreux, F.; Auboeuf, D. The multiple functions of RNA helicases as drivers and regulators of gene expression. Nat. Rev. Mol. Cell Biol. 2016, 17, 426–438. [Google Scholar] [CrossRef]
- Jankowsky, E. RNA helicases at work: Binding and rearranging. Trends Biochem. Sci. 2011, 36, 19–29. [Google Scholar] [CrossRef]
- Linder, P.; Jankowsky, E. From unwinding to clamping—The DEAD box RNA helicase family. Nat. Rev. Mol. Cell Biol. 2011, 12, 505–516. [Google Scholar] [CrossRef]
- Gorbalenya, A.E.; Koonin, E.V. Helicases: Amino acid sequence comparisons and structure-function relationships. Curr. Opin. Cell Biol. 1993, 3, 419–429. [Google Scholar] [CrossRef]
- Singleton, M.R.; Dillingham, M.S.; Wigley, D.B. Structure and mechanism of helicases and nucleic acid translocases. Annu. Rev. Biochem. 2007, 76, 23–50. [Google Scholar] [CrossRef]
- Fairman-Williams, M.E.; Guenther, U.-P.; Jankowsky, E. SF1 and SF2 helicases: Family matters. Curr. Opin. Cell Biol. 2010, 20, 313–324. [Google Scholar] [CrossRef] [PubMed]
- Panepinto, J.; Liu, L.; Ramos, J.; Zhu, X.; Valyi-Nagy, T.; Eksi, S.; Fu, J.; Jaffe, H.A.; Wickes, B.; Williamson, P.R. The DEAD-box RNA helicase Vad1 regulates multiple virulence-associated genes in Cryptococcus neoformans. J. Clin. Investig. 2005, 115, 632–641. [Google Scholar] [CrossRef]
- Ying, S.; Zhang, Z.; Zhang, Y.; Hao, Z.; Chai, R.; Qiu, H.; Wang, Y.; Zhu, X.; Wang, J.; Sun, G.; et al. MoDHX35, a DEAH-Box Protein, Is Required for Appressoria Formation and Full Virulence of the Rice Blast Fungus, Magnaporthe oryzae. Int. J. Mol. Sci. 2022, 23, 9015. [Google Scholar] [CrossRef]
- Seto, A.M.; Donaldson, M.E.; Saville, B.J. Exploring mechanisms of gene expression control during Ustilago maydis teliospore germination. Can. J. Plant Pathol. 2025, 47, 80–97. [Google Scholar] [CrossRef]
- Weaver, P.L.; Sun, C.; Chang, T.-H. Dbp3p, a putative RNA helicase in Saccharomyces cerevisiae, is required for efficient pre-rRNA processing predominantly at site A3. Mol. Cell. Biol. 1997, 17, 1354–1365. [Google Scholar] [CrossRef]
- Delaney, J.R.; Ahmed, U.; Chou, A.; Sim, S.; Carr, D.; Murakami, C.J.; Schleit, J.; Sutphin, G.L.; An, E.H.; Castanza, A.; et al. Stress profiling of longevity mutants identifies Afg3 as a mitochondrial determinant of cytoplasmic mRNA translation and aging. Aging Cell 2013, 12, 156–166. [Google Scholar] [CrossRef]
- Hilliker, A.; Gao, Z.; Jankowsky, E.; Parker, R. The DEAD-box protein Ded1 modulates translation by the formation and resolution of an eIF4F-mRNA complex. Mol. Cell 2011, 43, 962–972. [Google Scholar] [CrossRef] [PubMed]
- Aryanpur, P.P.; Regan, C.A.; Collins, J.M.; Mittelmeier, T.M.; Renner, D.M.; Vergara, A.M.; Brown, N.P.; Bolger, T.A. Gle1 regulates RNA binding of the DEAD-box helicase Ded1 in its complex role in translation initiation. Mol. Cell. Biol. 2017, 37, e00139-17. [Google Scholar] [CrossRef] [PubMed]
- Aryanpur, P.P.; Mittelmeier, T.M.; Bolger, T.A. The RNA Helicase Ded1 Regulates Translation and Granule Formation during Multiple Phases of Cellular Stress Responses. Mol. Cell. Biol. 2022, 42, e00244-21. [Google Scholar] [CrossRef] [PubMed]
- Seto, A.M.; Saville, B.J. Annotating the Ustilago maydis RNA helicases and predicting roles in pathogenic development. IMA Fungus 2025. Manuscript submitted. [Google Scholar]
- Edgar, R.C. MUSCLE: Multiple sequence alignment with high accuracy and high throughput. Nucleic Acids Res. 2004, 32, 1792–1797. [Google Scholar] [CrossRef]
- Waterhouse, A.M.; Procter, J.B.; Martin, D.M.A.; Clamp, M.; Barton, G.J. Jalview Version 2—A multiple sequence alignment editor and analysis workbench. Bioinformatics 2009, 25, 1189–1191. [Google Scholar] [CrossRef]
- Trifinopoulos, J.; Nguyen, L.-T.; von Haeseler, A.; Minh, B.Q. W-IQ-TREE: A fast online phylogenetic tool for maximum likelihood analysis. Nucleic Acids Res. 2016, 44, W232–W235. [Google Scholar] [CrossRef]
- Banuett, F. History of the Mating Types in Ustilago maydis. In Sex in Fungi; Wiley: Hoboken, NJ, USA, 2007; pp. 349–375. [Google Scholar]
- Bruce, S.A.; Saville, B.J.; Neil Emery, R.J. Ustilago maydis Produces Cytokinins and Abscisic Acid for Potential Regulation of Tumor Formation in Maize. J. Plant Growth Regul. 2011, 30, 51–63. [Google Scholar] [CrossRef]
- Kämper, J. A PCR-based system for highly efficient generation of gene replacement mutants in Ustilago maydis. Mol. Genet. Genom. 2004, 271, 103–110. [Google Scholar] [CrossRef]
- Kernkamp, M. Genetic and environmental factors affecting growth types of Ustilago zeae. Phytopathology 1939, 29, 473–484. [Google Scholar]
- Gold, S.; Duncan, G.; Barrett, K.; Kronstad, J. cAMP regulates morphogenesis in the fungal pathogen Ustilago maydis. Genes Dev. 1994, 8, 2805–2816. [Google Scholar] [CrossRef] [PubMed]
- Ruiz-Herrera, J.; León, C.G.; Guevara-Olvera, L.; Cárabez-Trejo, A. Yeast-mycelial dimorphism of haploid and diploid strains of Ustilago maydis. Microbiology (Read. Engl.) 1995, 141, 695–703. [Google Scholar] [CrossRef]
- Klose, J.; De Sá, M.M.; Kronstad, J.W. Lipid-induced filamentous growth in Ustilago maydis. Mol. Microbiol. 2004, 52, 823–835. [Google Scholar] [CrossRef]
- Gold, S.E.; Brogdon, S.M.; Mayorga, M.E.; Kronstad, J.W. The Ustilago maydis regulatory subunit of a cAMP-dependent protein kinase is required for gall formation in maize. Plant Cell 1997, 9, 1585–1594. [Google Scholar] [CrossRef]
- Raponi, M.; Arndt, G.M. Dominant genetic screen for cofactors that enhance antisense RNA-mediated gene silencing in fission yeast. Nucleic Acids Res. 2002, 30, 2546–2554. [Google Scholar] [CrossRef][Green Version]
- Donaldson, M.E.; Ostrowski, L.A.; Goulet, K.M.; Saville, B.J. Transcriptome analysis of smut fungi reveals widespread intergenic transcription and conserved antisense transcript expression. BMC Genom. 2017, 18, 340. [Google Scholar] [CrossRef]
- Ho, E.C.H.; Donaldson, M.E.; Saville, B.J. Detection of Antisense RNA Transcripts by Strand-Specific RT-PCR. In RT-PCR Protocols: Second Edition; King, N., Ed.; Humana Press: Totowa, NJ, USA, 2010; pp. 125–138. [Google Scholar]
- Chung, E.; Cho, C.-W.; Yun, B.-H.; Choi, H.-K.; So, H.-A.; Lee, S.-W.; Lee, J.-H. Molecular cloning and characterization of the soybean DEAD-box RNA helicase gene induced by low temperature and high salinity stress. Gene 2009, 443, 91–99. [Google Scholar] [CrossRef]
- Kant, P.; Kant, S.; Gordon, M.; Shaked, R.; Barak, S. STRESS RESPONSE SUPPRESSOR1 and STRESS RESPONSE SUPPRESSOR2, Two DEAD-Box RNA Helicases That Attenuate Arabidopsis Responses to Multiple Abiotic Stresses. Plant Physiol. 2007, 145, 814–830. [Google Scholar] [CrossRef] [PubMed]
- Khan, A.; Garbelli, A.; Grossi, S.; Florentin, A.; Batelli, G.; Acuna, T.; Zolla, G.; Kaye, Y.; Paul, L.K.; Zhu, J.-K.; et al. The Arabidopsis STRESS RESPONSE SUPPRESSOR DEAD-box RNA helicases are nucleolar- and chromocenter-localized proteins that undergo stress-mediated relocalization and are involved in epigenetic gene silencing. Plant J. 2014, 79, 28–43. [Google Scholar] [CrossRef] [PubMed]
- Wheeler, M.H. Comparisons of fungal melanin biosynthesis in ascomycetous, imperfect and basidiomycetous fungi. Trans. Br. Mycol. Soc. 1983, 81, 29–36. [Google Scholar] [CrossRef]
- Piepenbring, M.; Bauer, R.; Oberwinkler, F. Teliospores of smut fungi—General aspects of teliospore walls and sporogenesis. Protoplasma 1998, 204, 155–169. [Google Scholar] [CrossRef]
- Struhl, K. Nucleotide sequence and transcriptional mapping of the yeast pet56-his3-dedl gene region. Nucleic Acids Res. 1985, 13, 8587–8601. [Google Scholar] [CrossRef] [PubMed]
- Bottin, A.; Kämper, J.; Kahmann, R. Isolation of a carbon source-regulated gene from Ustilago maydis. Mol. Gen. Genet. 1996, 253, 342–352. [Google Scholar] [CrossRef]
- Aryanpur, P.P.; Renner, D.M.; Rodela, E.; Mittelmeier, T.M.; Byrd, A.; Bolger, T.A. The DEAD-box RNA helicase Ded1 has a role in the translational response to TORC1 inhibition. Mol. Biol. Cell 2019, 30, 2171–2184. [Google Scholar] [CrossRef]
- Carey, S.B.; List, H.M.; Siby, A.; Guerra, P.; Bolger, T.A. A synthetic genetic array screen for interactions with the RNA helicase DED1 during cell stress in budding yeast. G3 Genes Genomes Genet. 2023, 13, jkac296. [Google Scholar] [CrossRef]
- Buchan, J.R. mRNP granules. Assembly, function, and connections with disease. RNA Biol. 2014, 11, 1019–1030. [Google Scholar] [CrossRef]
- Forbes, K.C.; Humphrey, T.; Enoch, T. Suppressors of Cdc25p Overexpression Identify Two Pathways That Influence the G2/M Checkpoint in Fission Yeast. Genetics 1998, 150, 1361–1375. [Google Scholar] [CrossRef]
- Yoo, B.; Lee, C. Thermoprotective effect of sorbitol on protein during dehydration. J. Agric. Food Chem. 1993, 41, 190–192. [Google Scholar] [CrossRef]
- Loos, H.; Krämer, R.; Sahm, H.; Sprenger, G.A. Sorbitol promotes growth of Zymomonas mobilis in environments with high concentrations of sugar: Evidence for a physiological function of glucose-fructose oxidoreductase in osmoprotection. J. Bacteriol. 1994, 176, 7688–7693. [Google Scholar] [CrossRef]
- Santivarangkna, C.; Kulozik, U.; Kienberger, H.; Foerst, P. Changes in membrane fatty acids of Lactobacillus helveticus during vacuum drying with sorbitol. Lett. Appl. Microbiol. 2009, 49, 516–521. [Google Scholar] [CrossRef]
- Plante, S.; Moon, K.-M.; Lemieux, P.; Foster, L.J.; Landry, C.R. Breaking spore dormancy in budding yeast transforms the cytoplasm and the solubility of the proteome. PLOS Biol. 2023, 21, e3002042. [Google Scholar] [CrossRef]
- Van Laere, A. Trehalose, reserve and/or stress metabolite? FEMS Microbiol. Lett. 1989, 63, 201–209. [Google Scholar] [CrossRef]
- Van Laere, A.; Fransen, M. Metabolism of germinating teliospores of Ustilago nuda. Arch. Microbiol. 1989, 153, 33–37. [Google Scholar] [CrossRef]
- Caltrider, P.G.; Gottlieb, D. Respiratory activity and enzymes for glucose catabolism in fungus spores. Phytopathology 1963, 53, 1021–1030. [Google Scholar]
- Gottlieb, D.; Caltrider, P.G. Synthesis of enzymes during the germination of fungus spores. Nature 1963, 197, 916. [Google Scholar] [CrossRef] [PubMed]
- Ostrowski, L.A.; Seto, A.M.; Saville, B. Investigating teliospore germination using microrespiration analysis and microdissection. J. Vis. Exp. 2018, 135, e57628. [Google Scholar] [CrossRef]
- Allen, P.J. Metabolic Aspects of Spore Germination in Fungi. Annu. Rev. Phytopathol. 1965, 3, 313–342. [Google Scholar] [CrossRef]
- Tripathi, R.K.; Gottlieb, D. Sequential biosynthesis of ribonucleic acids during germination of teliospores of Ustilago maydis. Mycologia 1974, 66, 413–421. [Google Scholar] [CrossRef]
- Van Etten, J.L.; Roker, H.R.; Davies, E. Protein synthesis during fungal spore germination: Differential protein synthesis during germination of Botryodiplodia theobromae spores. J. Bacteriol. 1972, 112, 1029. [Google Scholar] [CrossRef]
- Holliday, R. The genetics of Ustilago maydis. Genet. Res. 1961, 2, 204–230. [Google Scholar] [CrossRef]
- Brachmann, A.; Konig, J.; Julius, C.; Feldbrugge, M. A reverse genetic approach for generating gene replacement mutants in Ustilago maydis. Mol. Genet. Genom. 2004, 272, 216–226. [Google Scholar] [CrossRef] [PubMed]
- Kumar, S.; Stecher, G.; Tamura, K. MEGA7: Molecular Evolutionary Genetics Analysis Version 7.0 for Bigger Datasets. Mol. Biol. Evol. 2016, 33, 1870–1874. [Google Scholar] [CrossRef]
- Wang, J.; Holden, D.W.; Leong, S.A. Gene transfer system for the phytopathogenic fungus Ustilago maydis. Proc. Natl. Acad. Sci. USA 1988, 85, 865–869. [Google Scholar] [CrossRef] [PubMed]
- Morrison, E.N.; Donaldson, M.E.; Saville, B.J. Identification and analysis of genes expressed in the Ustilago maydis dikaryon: Uncovering a novel class of pathogenesis genes. Can. J. Plant Pathol. 2012, 34, 417–435. [Google Scholar] [CrossRef]
- Hoffman, C.S.; Winston, F. A ten-minute DNA preparation from yeast efficiently releases autonomous plasmids for transformaion of Escherichia coli. Gene 1987, 57, 267–272. [Google Scholar] [CrossRef]
- Basse, C.W.; Stumpferl, S.; Kahmann, R. Characterization of a Ustilago maydis gene specifically induced during the biotrophic phase: Evidence for negative as well as positive regulation. Mol. Cell. Biol. 2000, 20, 329–339. [Google Scholar] [CrossRef]
- García-Pedrajas, M.D.; Nadal, M.; Denny, T.; Baeza-Montañez, L.; Paz, Z.; Gold, S.E. DelsGate: A Robust and Rapid Method for Gene Deletion. In Molecular and Cell Biology Methods for Fungi; Sharon, A., Ed.; Humana Press: Totowa, NJ, USA, 2010; pp. 55–76. [Google Scholar]
- Doyle, C.E.; Kitty Cheung, H.Y.; Spence, K.L.; Saville, B.J. Unh1, an Ustilago maydis Ndt80-like protein, controls completion of tumor maturation, teliospore development, and meiosis. Fungal Genet. Biol. 2016, 94, 54–68. [Google Scholar] [CrossRef]
- Sambrook, J.; Russell, D.W. Molecular Cloning: A Laboratory Manual; Cold Spring Harbor Laboratory Cold Spring: Harbor, NY, USA, 2001. [Google Scholar]
- Untergasser, A.; Cutcutache, I.; Koressaar, T.; Ye, J.; Faircloth, B.C.; Remm, M.; Rozen, S.G. Primer3—New capabilities and interfaces. Nucleic Acids Res. 2012, 40, e115. [Google Scholar] [CrossRef] [PubMed]
- Kõressaar, T.; Remm, M. Enhancements and modifications of primer design program Primer3. Bioinformatics 2007, 23, 1289–1291. [Google Scholar] [CrossRef] [PubMed]
- Kõressaar, T.; Lepamets, M.; Kaplinski, L.; Raime, K.; Andreson, R.; Remm, M. Primer3_masker: Integrating masking of template sequence with primer design software. Bot. Acta. 2018, 34, 1937–1938. [Google Scholar] [CrossRef] [PubMed]
- Donaldson, M.E.; Meng, S.; Gagarinova, A.; Babu, M.; Lambie, S.C.; Swiadek, A.A.; Saville, B.J. Investigating the Ustilago maydis/Zea mays pathosystem: Transcriptional responses and novel functional aspects of a fungal calcineurin regulatory B subunit. Fungal Genet. Biol. 2013, 58–59, 91–104. [Google Scholar] [CrossRef]
- Cheung, H.Y.K.; Donaldson, M.E.; Storfie, E.R.M.; Spence, K.L.; Fetsch, J.L.O.; Harrison, M.C.; Saville, B.J. Zfp1, a putative Zn(II)2Cys6 transcription factor, influences Ustilago maydis pathogenesis at multiple stages. Plant Pathol. 2021, 70, 1626–1639. [Google Scholar] [CrossRef]

| Strain | Relevant Genotype * | Source |
|---|---|---|
| Wild-type | ||
| 518 | a2 b2 | Holliday [67] |
| 521 | a1 b1 | Holliday [67] |
| uded1 Mutants | ||
| 518 crg1:uded1 | a2 b2 crg1:uded1::cbxR | This study |
| 521 crg1:uded1 | a1 b1 crg1:uded1::cbxR | This study |
| 518Δuded1 crg1:uded1 | a2 b2 Δuded1::hphR crg1:uded1::cbxR | This study |
| 521Δuded1 crg1:uded1 | a1 b1 Δuded1::hphR crg1:uded1::cbxR | This study |
| 518 crg1:uded1 [pCM768] | a2 b2 crg1:uded1::cbxR [pCM768] | This study |
| 521 crg1:uded1 [pCM768] | a1 b1 crg1:uded1::cbxR [pCM768] | This study |
| 518 crg1:uded1 [pCMas-ssm1] | a2 b2 crg1:uded1::cbxR [pCMas-ssm1] | This study |
| 521 crg1:uded1 [pCMas-ssm1] | a1 b1 crg1:uded1::cbxR [pCMas-sm1] | This study |
| udbp3 Mutants | ||
| 518Δudbp3 | a2 b2 Δudbp3::hphR | This study |
| 521Δudbp3 | a1 b1 Δudbp3::cbxR | This study |
Disclaimer/Publisher’s Note: The statements, opinions and data contained in all publications are solely those of the individual author(s) and contributor(s) and not of MDPI and/or the editor(s). MDPI and/or the editor(s) disclaim responsibility for any injury to people or property resulting from any ideas, methods, instructions or products referred to in the content. |
© 2025 by the authors. Licensee MDPI, Basel, Switzerland. This article is an open access article distributed under the terms and conditions of the Creative Commons Attribution (CC BY) license (https://creativecommons.org/licenses/by/4.0/).
Share and Cite
Seto, A.M.; Saville, B.J. Characterization of RNA Helicase Genes in Ustilago maydis Reveals Links to Stress Response and Teliospore Dormancy. Int. J. Mol. Sci. 2025, 26, 2432. https://doi.org/10.3390/ijms26062432
Seto AM, Saville BJ. Characterization of RNA Helicase Genes in Ustilago maydis Reveals Links to Stress Response and Teliospore Dormancy. International Journal of Molecular Sciences. 2025; 26(6):2432. https://doi.org/10.3390/ijms26062432
Chicago/Turabian StyleSeto, Amanda M., and Barry J. Saville. 2025. "Characterization of RNA Helicase Genes in Ustilago maydis Reveals Links to Stress Response and Teliospore Dormancy" International Journal of Molecular Sciences 26, no. 6: 2432. https://doi.org/10.3390/ijms26062432
APA StyleSeto, A. M., & Saville, B. J. (2025). Characterization of RNA Helicase Genes in Ustilago maydis Reveals Links to Stress Response and Teliospore Dormancy. International Journal of Molecular Sciences, 26(6), 2432. https://doi.org/10.3390/ijms26062432

